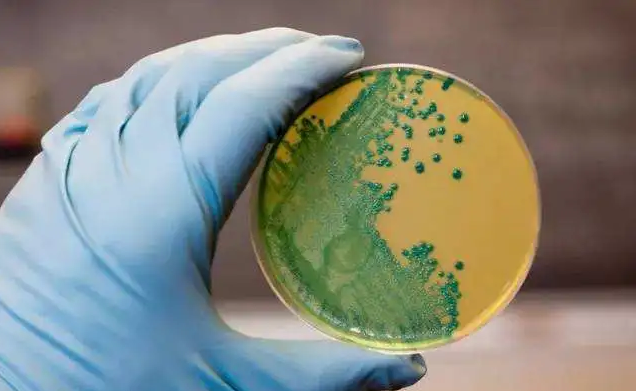
4

美国大量土豆、柠檬、酸橙被召回,主因竟是这个“冰箱杀手”
来源: 发布时间:2020-08-19
在接连的沙门氏菌感染事件后,美国又爆出了食品安全问题。
美国食品药品监督管理局(FDA)宣布大量农产品被召回,因存在被李斯特菌污染的可能。
此次召回是在一家包装工厂的设备上发现单核增生李斯特菌后发布的。该公司负责人在一份声明中说:“我们出于谨慎而主动宣布召回,将对公众健康的哪怕是最轻微的风险降到最低。”受影响的产品包括新鲜酸橙、有机酸橙、红薯和柠檬,以及威格曼斯柠檬和加州瓦伦西亚橙子。
“冰箱杀手”李斯特菌

李斯特菌是一种致病细菌,国际上公认的李斯特菌共有七个菌株,其中单增李斯特菌是唯一能引起人类疾病的。它在自然界中广泛存在,在泥土、植物、动物饲料以及人类和动物粪便当中都可以找到它的身影。因为无处不在,使得李斯特菌容易污染的食品,进而引起人类的食源性疾病。李斯特菌有一个外号叫“冰箱杀手”,因为它在0-45℃都能生存,尤其在冰箱的冷藏温度下仍可以生长繁殖,甚至在-20℃的冷冻室也能存活1年,不过,好在李斯特菌并不耐热。
有利李斯特菌繁殖的条件:

健康成年人感染李斯特菌的几率较低,即使感染一般也不会导致严重后果。但对于孕妇、儿童、老年人及免疫力低下的人群(如糖尿病、肿瘤患者),李斯特菌却可能带来相当严重的后果。主要包括类似感冒症状、恶心、呕吐、腹部痉挛、腹泻、头痛、便秘及持续发烧,严重的感染个案也可能出现败血病和脑膜炎。李斯特菌极容易污染食品,其中冷藏食品和即食食品危害最为严重,很多国家都已经采取措施来控制食品中的李斯特菌,并制定了相应的标准。
国内外关于食品中李斯特菌限量的规定
2007年国际食品法典委员会通过了《应用食品卫生通则控制食品中单增李斯特菌的指南》(CAC/GL 61-2007),其中对单增李斯特菌容易生长繁殖的即食食品规定n=5,c=0,m=0 CFU/25g的限量要求,而对单增李斯特菌不易生长繁殖的即食食品则规定为n=5,c=0,m=100 CFU/g的限量。
此次新闻事件的主角美国对即食食品中单增李斯特菌的限量规定为 0/25g,并要求企业实施 GHP 和HACCP。
日本规定了非加热肉食制品和天然奶酪中的李斯特菌的限量要求为 100 cfu/g,其他产品中没有规定李斯特菌的限量要求。

韩国规定了食用肉制品(生产、加工用原料除外)以及那些无需其他加工、无需加热直接食用的杀菌或灭菌产品中的李斯特菌限量要求:n=5,c=0,m=0/25 g(注:n为同一批次产品应采集的样品件数;c为最大可允许超出m值的样品数;m为致病菌指标可接受水平的限量值)。
中国大陆 2013 年颁布的《食品中致病菌限量标准 GB29921-2013》中规定,在即食肉制品中,单增李斯特菌按照二级采样方法取样不得检出(n=5,c=0,m=0)。
我国现行食品安全标准及相关法规分别对部分高危食品规定了单增李斯特菌的限量要求及相关检验方法。包括《食品安全国家标准 干酪》(GB5420-2010),《食品安全国家标准 再制干酪》(GB25192-2010),《食品安全国家标准 食品中致病菌限量》(GB29921-2013)等为食品安全风险控制提供了科学参考和监管依据。根据相关标准要求,干酪、再制干酪、熟肉制品和即食生肉制品中均不得检出单增李斯特菌。
易受单增李斯特菌污染的高危食品
单核细胞增生李斯特氏菌主要以食物为传染媒介,是最致命的食源性病原体之一,其致死率甚至高过沙门氏菌及肉毒杆菌。李斯特菌最容易污染的食品为乳和乳制品、肉和肉制品、蔬菜、沙拉、海产品和冰淇淋等,尤其是冰箱中保存时间过长的乳制品、肉制品最为常见。
针对单增李斯特菌,2004年世界粮农组织/世界卫生组织对即食食品中单增李斯特菌进行了风险评估并发布了评估报告,报告指出食源性李斯特菌病与食品中单增李斯特菌的污染浓度及被污染食品的摄入量密切相关。因而控制原料的污染,妥善处理食品才是解决问题的关键。

控制原料污染、严格食品处理工程,对于食品企业来说自然是必然的选择。食品安全问题,食品企业作为 “第一责任人”,必然会面临政府的监管,消费者的监督,在经济利益和销量面前,食品安全也不可懈怠,企业只有规范生产程序,利用专业的检测技术,维护好企业“第一责任人”的责任意识,才能真正促进食品行业健康发展。